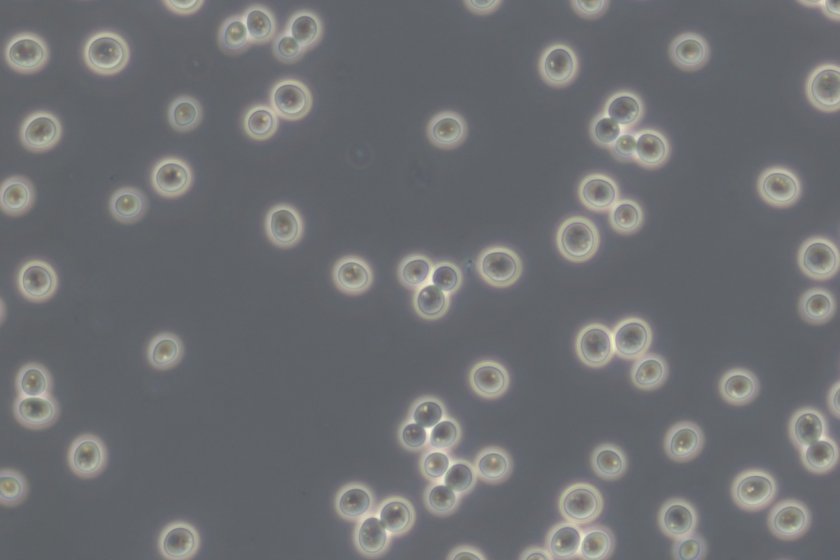

category_news
Start-up ontwikkelt fabriekjes van gist die waardevolle stoffen produceren
Gist wordt al eeuwen gebruikt voor de productie van wijn en brood. Wetenschappers kunnen gistcellen aanpassen zodat ze ook andere producten maken, maar dat is een lang en moeizaam proces. Carina Nieuwenweg en Angelina Horsting hebben daar iets op gevonden: met behulp van CRISPR-Cas kunnen ze gist snel en doelgericht ombouwen tot een ‘microfabriekje’ dat waardevolle stoffen produceert.
Microbioloog Carina Nieuwenweg kwam tijdens haar PhD in aanraking met onderzoek naar gist. ‘Ik hield me bezig met het aanpassen van het DNA van gist, en dat werkte best goed. Toen dacht ik: moeten we dit niet patenteren?’
Na het afronden van haar PhD in 2024 besloot Nieuwenweg zich verder te verdiepen in haar DNA-onderzoek. Met ondersteuning van Wageningen University & Research (WUR) richtte ze Novya Biotech op, een deeptech-start-up. ‘Eerst hield ik me vooral bezig met de wetenschap, maar daarna moest ik ook aan business development gaan denken. Dat werd wel heel veel. Daarom ging ik op zoek naar iemand die dezelfde energie heeft als ik.’
Precies op het juiste moment kwam ze Angelina Horsting tegen, die een extra uitdaging zocht naast haar werk als sociale wetenschapper bij WUR. De twee kenden elkaar nog van de bachelor Moleculaire Levenswetenschappen, waar ze samen studentenprojecten hadden gedaan.
Bier, brood en insuline
Novya is gericht op het ontwikkelen van toepassingen voor gist. Deze nuttige schimmel is essentieel voor de productie van onder meer bier, brood en wijn. Maar gisten kunnen ook andere stoffen produceren; sinds de jaren 50 wordt er bijvoorbeeld al insuline mee gemaakt. Voor het maken van nieuwe producten moet het DNA van de gistcel worden aangepast. ‘Het aanpassen van DNA was altijd een bottleneck’, zegt Nieuwenweg. ‘Het kon jaren of zelfs decennia duren, het ging echt stapje voor stapje. Met onze technologie kunnen we dat proces versnellen. Dan gaat het exponentieel in plaats van lineair.’
De technologie van Novya maakt het mogelijk om succesvolle genetische modificaties te hergebruiken. Door die ‘op elkaar te stapelen’ kunnen gistcellen snel en rendabel op maat worden gemaakt. Hierbij wordt gebruik gemaakt van CRISPR-Cas, een techniek waarmee wetenschappers DNA nauwkeurig kunnen aanpassen. Nieuwenweg deed haar promotieonderzoek bij de onderzoeksgroep van John van der Oost en Raymond Staals, pioniers op het gebied van CRISPR-Cas. Nu vallen Nieuwenweg en Horsting onder de groep Systems & Synthetic Biology, die veel expertise over gist in huis heeft.
Zelf medicijnen maken?
Met hun gisttechnologie kunnen Nieuwenweg en Horsting aromatische stoffen maken. Daar zijn verschillende toepassingen voor, zegt Horsting: ‘We zijn verschillende markten aan het analyseren, zoals de food-, cosmetica- en farmaceutische sector. Die hebben allemaal hun eigen regels en eigenschappen, en we moeten ook nadenken over welke partijen dan geïnteresseerd zouden zijn.’
Maar voordat Novya de stap naar de markt zet, moeten er eerst belangrijke tussenstappen worden gezet. ‘We werken nu aan generieke verbeteringen voor gistcellen’, zegt Nieuwenweg. ‘Je kunt gist zien als een “microfabriekje”, dat producten maakt op basis van zijn DNA. Dat fabriekje zijn we aan het optimaliseren.’
Het zou mooi zijn als we bijvoorbeeld medicijnen of voedingsingrediënten kunnen produceren die nu buiten Europa worden gemaakt
In de toekomst hopen Nieuwenweg en Horsting zoveel mogelijk impact te maken met hun start-up. Horsting: ‘Het zou mooi zijn als we bijvoorbeeld medicijnen of voedingsingrediënten kunnen produceren die nu buiten Europa worden gemaakt, zodat we minder afhankelijk worden en beter bestand zijn tegen geopolitieke spanningen.’ Gist zou bijvoorbeeld kleur- en geurstoffen kunnen produceren, of moleculen zoals taxol. Deze stof, die wordt gebruikt voor chemotherapie, is moeilijk na te maken en wordt nu gewonnen uit de taxusplant. ‘Een plant maakt stofjes in lage concentraties. Dat zou met gist effectiever en duurzamer kunnen’, zegt Nieuwenweg.
Hulp van experts en studenten
Novya heeft veel hulp gekregen van WUR, zegt Carina Nieuwenweg. ‘Bijvoorbeeld bij het aanvragen van fondsen. We krijgen ook ondersteuning van assistant professor Stefan Hoffmann, gistexpert bij het Laboratory of Systems and Synthetic Biology en van business developers. Zij voorkomen dat we hele grove fouten maken!’ Studenten kunnen ook bijdragen aan de groei van Novya, zegt Nieuwenweg: ‘We zouden heel blij zijn met studenten die hun thesis gaan schrijven en die ons willen helpen in het lab, of met de business development.’
F&A Next
Meerdere veelbelovende start-ups, waaronder Novya, nemen deel aan F&A Next. Dit is een internationale conferentie voor duurzame innovatie binnen de Food & Agri sector. F&A Next vindt plaats op 21 en 22 mei in Wageningen.